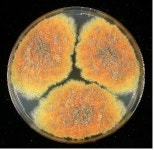
세계는 지금 미생물 유전자원 확보 경쟁 중

나도 바이오(NADO bio) 총73명이 열람하였으며, 0개의 리뷰가 있습니다.
- 번호
- 56,833
- 개방서비스명
- 의료기기판매(임대)업
- 개방서비스아이디
- 01_02_03_P
- 개방자치단체코드
- 3,230,000
- 관리번호
- PHMG120233230034047000140
- 인허가일자
- 2023-06-28
- 영업상태구분코드
- 1
- 영업상태명
- 영업/정상
- 상세영업상태코드
- 13
- 상세영업상태명
- 영업중
- 소재지전체주소
- 서울특별시 송파구 풍납동 ***-* 쌍용아파트 ***동 ***호
- 도로명전체주소
- 서울특별시 송파구 올림픽로**길 *, ***동 ***호 (풍납동, 쌍용아파트)
- 도로명우편번호
- 5,538
- 사업장명
- 나도 바이오(NADO bio)
- 최종수정시점
- 2024-05-10 17:16:45
- 데이터갱신구분
- U
- 데이터갱신일자
- 2024-05-12 02:40:00
- 좌표정보x(epsg5174)
- 127
- 좌표정보y(epsg5174)
- 38
주변 목록 (8)
테크포랩
서울특별시 송파구 풍납동 ***번지 *호 쌍용(아)상가 *층*호
'나도 바이오(NADO bio)'에서 0km
서울특별시 송파구 풍납동 ***번지 *호 쌍용(아)상가 *층*호
바로가기
에이치메디
서울특별시 송파구 풍납동 ***-* 쌍용아파트
'나도 바이오(NADO bio)'에서 0km
서울특별시 송파구 풍납동 ***-* 쌍용아파트
바로가기
시그니아독일보청기(올림픽센터)
서울특별시 송파구 풍납*동 ***번지 *호 *층
'나도 바이오(NADO bio)'에서 0.1km
서울특별시 송파구 풍납*동 ***번지 *호 *층
바로가기
㈜코리아세븐 풍납사거리점
서울특별시 송파구 풍납동 ***-* J 빌딩
'나도 바이오(NADO bio)'에서 0.1km
서울특별시 송파구 풍납동 ***-* J 빌딩
바로가기
호드림
서울특별시 송파구 풍납동 ***-* ***동 ****호
'나도 바이오(NADO bio)'에서 0.1km
서울특별시 송파구 풍납동 ***-* ***동 ****호
바로가기
㈜노보잼코리아
서울특별시 송파구 풍납동 *** 오성빌딩
'나도 바이오(NADO bio)'에서 0.2km
서울특별시 송파구 풍납동 *** 오성빌딩
바로가기
세븐일레븐풍납센터점
서울특별시 송파구 풍납동 *** ***호
'나도 바이오(NADO bio)'에서 0.2km
서울특별시 송파구 풍납동 *** ***호
바로가기
동성의료기상사
서울특별시 송파구 풍납동 ***번지 **호 동성빌딩
'나도 바이오(NADO bio)'에서 0.2km
서울특별시 송파구 풍납동 ***번지 **호 동성빌딩
바로가기
주변 의료기기 수리업 (12)
시그니아독일보청기(올림픽센터)
서울특별시 송파구 풍납동 401번지 2호 2층
'나도 바이오(NADO bio)'에서 0.07km
바로가기
조인메디칼(주)
서울특별시 강동구 성내동 452번지 3호 302호
'나도 바이오(NADO bio)'에서 0.32km
바로가기
누리메디칼
서울특별시 강동구 성내동 459-6 상광빌딩 204호
'나도 바이오(NADO bio)'에서 0.37km
바로가기
알앤에스
서울특별시 강동구 성내동 458-7 리치빌
'나도 바이오(NADO bio)'에서 0.42km
바로가기
트윈메디텍
서울특별시 송파구 풍납동 222번지 134호
'나도 바이오(NADO bio)'에서 0.74km
바로가기
메디팩토리
서울특별시 강동구 성내동 590 성내동삼성아파트 상가동 112호
'나도 바이오(NADO bio)'에서 0.83km
바로가기
영인메디칼
서울특별시 강동구 성내동 543번지 4호 102호
'나도 바이오(NADO bio)'에서 0.92km
바로가기
글래드얼라이언스
서울특별시 강동구 성내동 469번지 6호
'나도 바이오(NADO bio)'에서 0.93km
바로가기
다올메디칼
서울특별시 강동구 성내동 446번지 20호
'나도 바이오(NADO bio)'에서 1.08km
바로가기
알티에스
서울특별시 강동구 성내동 43-11 G라이트빌딩
'나도 바이오(NADO bio)'에서 1.25km
바로가기
주식회사 웰니스온
서울특별시 송파구 방이동 51 올림픽파크리움
'나도 바이오(NADO bio)'에서 1.32km
바로가기
온누리보청기
서울특별시 강동구 천호동 454-15 동원천호빌딩
'나도 바이오(NADO bio)'에서 1.44km
바로가기
주변 부속 의료기관 (12)
씨젠부속의원
서울특별시 송파구 방이동 22-3 씨젠송파빌딩
'나도 바이오(NADO bio)'에서 1.64km
바로가기
삼성에스디에스(주)부속의원
'나도 바이오(NADO bio)'에서 1.95km
바로가기
서울동부지방법원부속의원
서울특별시 송파구 문정동 650번지 서울동부지방법원
'나도 바이오(NADO bio)'에서 4.87km
바로가기
메디톡스부속의원
서울특별시 강남구 대치동 997번지 4호 지하1층
'나도 바이오(NADO bio)'에서 4.95km
바로가기
서울동부구치소부속의원
서울특별시 송파구 문정동 648번지
'나도 바이오(NADO bio)'에서 5.03km
바로가기
삼성물산(주)부속의원
'나도 바이오(NADO bio)'에서 5.62km
바로가기
삼성물산(주)부속치과의원
'나도 바이오(NADO bio)'에서 5.62km
바로가기
삼성이앤에이(주) 부속의원
'나도 바이오(NADO bio)'에서 5.62km
바로가기
멀츠아시아퍼시픽피티이엘티디(영업소)부속의원
서울특별시 강남구 삼성동 158번지 16호 엔씨타워 I, 4층일부
'나도 바이오(NADO bio)'에서 5.68km
바로가기
메디스트림부속한의원
서울특별시 강남구 삼성동 143-40 위워크타워 3층 일부
'나도 바이오(NADO bio)'에서 6.11km
바로가기
경희무릅나무한의원 부속 원외탕전실
경기도 남양주시 수석동 370번지 2호 1층
'나도 바이오(NADO bio)'에서 8.1km
바로가기
바디프랜드부속의원
서울특별시 강남구 도곡동 448-2 바디프랜드 도곡타워
'나도 바이오(NADO bio)'에서 8.26km
바로가기
주변 의료 유사업 (12)
늘함안마원
'나도 바이오(NADO bio)'에서 1.65km
바로가기
건강한지압안마원
서울특별시 송파구 방이동 110번지 6호
'나도 바이오(NADO bio)'에서 1.77km
바로가기
은혜안마원
서울특별시 강동구 길동 364번지 12호 2층
'나도 바이오(NADO bio)'에서 2.49km
바로가기
MR강안마원
서울특별시 강동구 천호동 238번지 1호
'나도 바이오(NADO bio)'에서 2.58km
바로가기
석민지압안마원
서울특별시 강동구 천호동 45-10 1층
'나도 바이오(NADO bio)'에서 2.82km
바로가기
명지압안마원
서울특별시 광진구 자양동 679-28 태솔타운 1동 201호
'나도 바이오(NADO bio)'에서 2.92km
바로가기
팜스케어안마원
서울특별시 송파구 석촌동 295번지 9호 3층
'나도 바이오(NADO bio)'에서 2.94km
바로가기
디올안마시술소
서울특별시 광진구 자양동 216번지 4호
'나도 바이오(NADO bio)'에서 3km
바로가기
이성호안마원
서울특별시 광진구 구의동 252번지 128호 201호
'나도 바이오(NADO bio)'에서 3.17km
바로가기
소망지압안마원
서울특별시 강동구 천호동 29번지 28호 1층
'나도 바이오(NADO bio)'에서 3.18km
바로가기
힐링스토리
서울특별시 광진구 자양동 626-2 1층
'나도 바이오(NADO bio)'에서 3.19km
바로가기
청평안마원
서울특별시 송파구 석촌동 210번지 공익빌딩 405호
'나도 바이오(NADO bio)'에서 3.32km
바로가기
주변 의료법인 (12)
의료법인 정애의료재단
서울특별시 송파구 풍납동 496번지 5호
'나도 바이오(NADO bio)'에서 0.79km
바로가기
의료법인 성심의료재단
'나도 바이오(NADO bio)'에서 1.83km
바로가기
의료법인 문원의료재단
서울특별시 송파구 가락본동 2번지 3-4
'나도 바이오(NADO bio)'에서 2.67km
바로가기
의료법인 혜민재단
서울특별시 광진구 자양동 627번지 3호
'나도 바이오(NADO bio)'에서 3.15km
바로가기
의료법인유투의료재단
서울특별시 송파구 마천동 42번지 7호
'나도 바이오(NADO bio)'에서 4.1km
바로가기
의료법인 대진의료재단
서울특별시 광진구 중곡동 58번지 25호
'나도 바이오(NADO bio)'에서 4.39km
바로가기
의료법인일맥의료재단
서울특별시 송파구 문정동 17-5 인애가한방병원
'나도 바이오(NADO bio)'에서 4.56km
바로가기
의료법인 가산의료재단
서울특별시 강남구 삼성1동 161번지
'나도 바이오(NADO bio)'에서 5.11km
바로가기
의료법인미래의료재단
'나도 바이오(NADO bio)'에서 5.61km
바로가기
의료법인 주은혜의료재단
서울특별시 성동구 용답동 235번지 8호
'나도 바이오(NADO bio)'에서 5.79km
바로가기
의료법인중앙의료재단
서울특별시 강남구 자곡동 633 S-플라자 3층 303호
'나도 바이오(NADO bio)'에서 6.47km
바로가기
의료법인 운양의료재단
경기도 구리시 수택동 853번지
'나도 바이오(NADO bio)'에서 7.45km
바로가기
주변 병원 (12)
포레스트한방병원
서울특별시 강동구 성내동 452 지하3, 지하1 일부, 1~5층
'나도 바이오(NADO bio)'에서 0.26km
바로가기
청병원
'나도 바이오(NADO bio)'에서 0.45km
바로가기
의료법인일맥의료재단 강동인애가한방병원
서울특별시 강동구 성내동 551번지 3호 인애가한방병원
'나도 바이오(NADO bio)'에서 0.5km
바로가기
동행한방병원
서울특별시 송파구 풍납동 269-3 지하1~지상5층
'나도 바이오(NADO bio)'에서 0.57km
바로가기
재단법인아산사회복지재단 서울아산병원
서울특별시 송파구 풍납동 388번지 1호 서울아산병원
'나도 바이오(NADO bio)'에서 0.73km
바로가기
더셀채원병원
서울특별시 강동구 성내동 548번지 5호 채원자연통합병원빌딩
'나도 바이오(NADO bio)'에서 0.82km
바로가기
공안과병원
'나도 바이오(NADO bio)'에서 1.04km
바로가기
리더스병원
'나도 바이오(NADO bio)'에서 1.4km
바로가기
서울미즈병원
서울특별시 강동구 천호동 452-1
'나도 바이오(NADO bio)'에서 1.47km
바로가기
조은마디병원
서울특별시 강동구 성내동 199번지 5호
'나도 바이오(NADO bio)'에서 1.6km
바로가기
아이엠치과병원
서울특별시 강동구 천호동 425-5 대우 한강 베네시티
'나도 바이오(NADO bio)'에서 1.62km
바로가기
다나움요양병원
서울특별시 송파구 방이동 160
'나도 바이오(NADO bio)'에서 1.66km
바로가기
블로그 리뷰
-
AIBIO 리커버리랩스 후기 ~~ 마곡동에서 바이오펄스 체험해봄! 얼마 전에 서울 강서구 마곡동 798-3... 레드라이트 후기를 찾아보면 실제로 피로감 개선에 도움됐다는 말이 많더라. 다음에는 나도 그거...
Jet Punch 다이어리(20250429)

-
대사증후군 관리 AIBIO 리커버리랩스 후기 주소 : 서울 강서구 마곡동 798-3, 403호 ⏰운영시간 10:00 - 21:00... 이 곳은 바이오해킹을 해서 살을 왜 빼지 못하는지, 만성피로를 왜 달고 사는지 등 근본적인 것들부터...
여행 좋아하는 먹잘알 빛나(20250529)

-
Bio Fishing! )) 바이오 입니다! 퍄~~ 지난번 출조에서 무려 57cm 런커를 잡아내며 기록갱신을 했었죠... 히히 그 사진에서만 보던 어망가득 배스를 드디어 나도 겪는건가? ㅎㅎㅎ 그리하야~~ 오늘의 출조지!!...
『Bio Bass. Bio Fishing!』(20260430)

-
나도 매우 생소했는데, 좋은 기회로 직접 체험해 볼 수 있어서 기쁜 마음으로 달려왔다. 마곡역 6번... 나는 이 날, 바이오펄스 체험을 해 보았다. 체험을 하러 온 것을 몸이 어떻게 알았는지, 허리가 살살 아픈...
여니로그(20250228)

-
<나도 몰랐던 내 피부 상태를 측정해보세요! 얄사장의 아이오페 바이오랩 방문기> 안녕하세요... 그래서 얄사장은 내 피부 상태를 좀 더 정확하게 진단하고 상담하기 위해서 아이오페 바이오랩(BIO LAB)에...
얄사장의 Bloom your Style(20140304)

-
임산부 튼살관리 오일 추천 바이오오일 스킨케어 오일 실사용 후기 임신 하자마자 가장 고민 됐던 튼살....!!! 애 셋을 낳은 엄마 배를 보면 나도 엄마 살성을 닮으면 살 엄청 트겠구나 싶어서 무조건 임신하면...
오늘의 기록(20260526)

-
직접 경험한 후기 나는 세포활성화, 안티에이징, 화이트태닝에 도움을 주는 바이오레드라이트를... 나도 사장님께 부탁드려 받아봤는데 일단 기본적인 근육량이나 지방량 등을 보시더니 전문적으로...
셍로그, 행복은 지금 여기에.(20250805)

-
아이허브 바이오 오일 바이오 오일 후기 시중에서도 쉽게 구할수있는 바이오 오일 아이허브에서도... ^^ 나도 얼굴은 무섭고 바디용으로 샀음.. 치덕치덕 발라야지.ㅠㅠ 건조건조.ㅠㅠ 주둥이.. 확 쏟아지지...
반짝반짝 빛나는 ★(20151126)

-
아무튼 로션 바르고 아정이 얼굴을 보는데 시간이 꽤나 지나도 촉촉한 게 보였다 사진으로 제대로... 닥터바이오 홈페이지 주소 & <본 포스팅은 업체로부터 제품만을 제공받아 직접 체험 후 작성된 후기입니다>
Boritangu's Story(20211116)

-
SIGNATURE BIO AMPOILE Celonia 애정하는 #르뷰 #얼루어 찬스 피부의 시간을 되돌리다 Celonia SIGNATURE BIO AMPOILE 셀로니아 시그니처 바이오 앰플 암요 암요 시간을 정말 되돌리고 싶다 그런데 지금 내 나이의 나도...
JU de MAME by JURl(20200405)

일별 방문 통계
월별 방문 통계
카카오맵 바로가기
카카오맵 위치 기준 길안내
리뷰 (0)
등록된 리뷰가 없습니다.
관련 지도 선택 및 번역
첨부파일